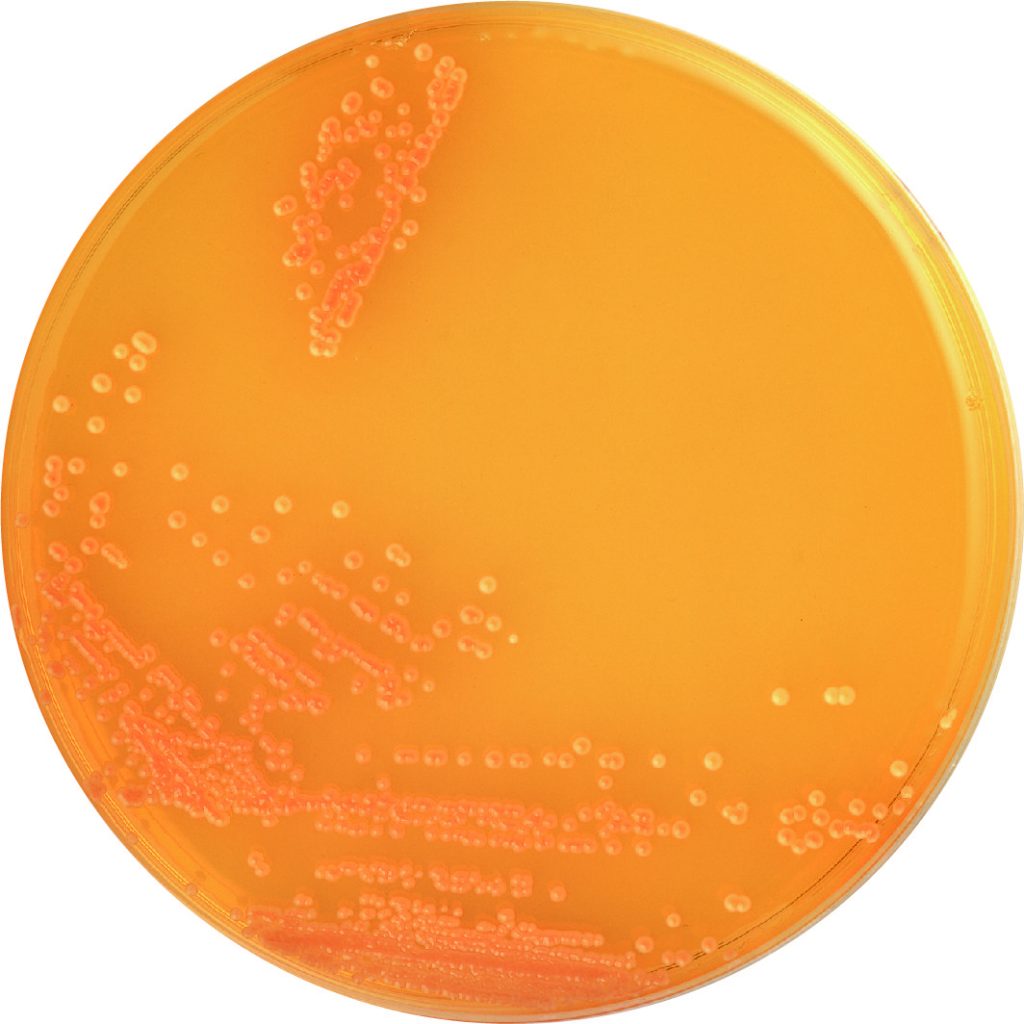

Mikrobiológiai táptalajok – dehidratált és sejttenyésztő médiumok
A mikrobiológiai táptalajok alapvető szerepet töltenek be a laboratóriumi diagnosztikában, élelmiszerbiztonságban, gyógyszeripari minőségellenőrzésben és kutatás-fejlesztésben. A megfelelő táptalaj kiválasztása kulcsfontosságú a mikroorganizmusok megbízható kimutatásához, izolálásához és számlálásához.
Elérhető táptalajok
Anaerob mikroorganizmusok izolálása, tenyésztése és érzékenységi vizsgálata
GAM Agar (Gifu Anaerobic Medium Agar)
- Általános anaerob baktériumok tenyésztésére
GAM Broth (Gifu Anaerobic Medium Broth)
- Anaerob baktériumok dúsítására és folyadéktenyésztésére
GAM Agar – modified
- Módosított összetételű szilárd táptalaj speciális anaerob tenyésztési és vizsgálati alkalmazásokhoz
GAM Broth – modified
- Módosított folyékony táptalaj anaerob baktériumok célzott tenyésztéséhez
CW Agar Base (kanamicin nélkül)
- Clostridium perfringens izolálására, különösen hőkezelt élelmiszerminták vizsgálatához
BL Agar
- Anaerob baktériumok izolálására és Bifidobacterium fajok differenciálására
Clostridia Count Agar
- Élelmiszermintákban előforduló Clostridium fajok számlálására
Vibrio parahaemolyticus és Vibrio cholerae dúsítása és kimutatása
- Salt Polymyxin Broth
- Vibrio parahaemolyticus szelektív dúsítására
- Alkaline Peptone Water
- V. cholerae és V. parahaemolyticus dúsítására
- X-VP Agar
- Vibrio fajok izolálására és differenciálására
Bacillus cereus kimutatása
NGKG Agar Base
- Szelektív táptalaj Bacillus cereus izolálására és azonosítására
Élesztők és gombák tenyésztése
- Candida GE Agar
- Candida fajok szelektív tenyésztésére klinikai és ipari mintákból
Általános célú médiumok aerob és anaerob baktériumok tenyésztésére
Trypto-Soya Broth (SCD Broth)
- Általános célú folyékony táptalaj fastidious baktériumok és vérkultúrák tenyésztésére
Trypto-Soya Agar (SCD Agar)
- Széles spektrumú, nem szelektív szilárd táptalaj
TGC Broth Medium (indikátor nélkül)
- Aerob és anaerob baktériumok tenyésztésére
Enterobaktériumok differenciálása
DHL Agar (Desoxycholate Hydrogen Sulfide Lactose Agar)
- Salmonella, Shigella és patogén E. coli izolálására és elkülönítésére
Vitamin assay táptalajok – mikrobiológiai vitamin-meghatározási vizsgálatokhoz
- Lactobacilli Inoculum Broth
- Vitamin B12 Assay Medium
- Pyridoxine Assay Medium
- Folic Acid Assay Medium
- Biotin Assay Medium
Sejttenyésztő médiumok
Eagle’s MEM
- Autoklávozható por formájú sejttenyésztő médium HeLa és egyéb sejtvonalak növekedéséhez
Elérhető változatok:
- kanamicinnel
- fenolvörössel vagy anélkül
- L-glutamin és nátrium-hidrogénkarbonát nélkül
Vegye fel velünk a kapcsolatot, és segítünk kiválasztani az adott vizsgálati célhoz legmegfelelőbb médiumot és kiszerelést.